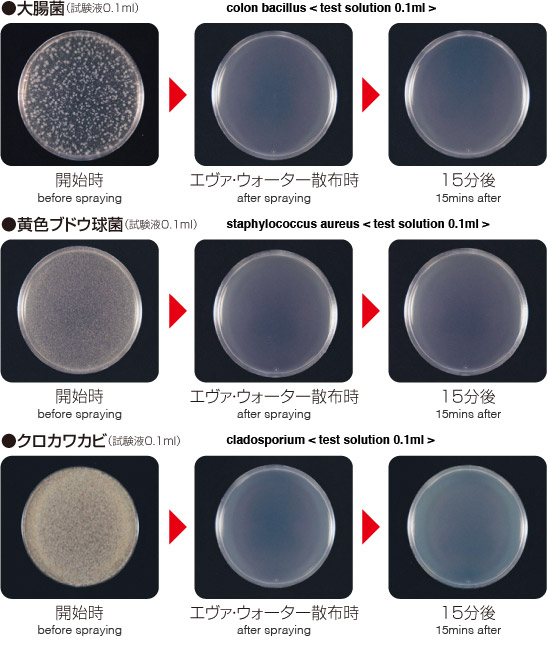
実験イメージ

エヴァウォーターは、しっかりと「財団法人 日本食品分析センター」や他の機関でも調査しております。
その結果は以下の通りです。
| 試験菌 | 対象 | 生菌数(/ml) | |||
|---|---|---|---|---|---|
| 開始時* | 1分後 | 5分後 | 15分後 | ||
| 大腸菌 | 検体 | 8.0×105 | <10 | <10 | <10 |
| 対照 | 4.8×105 | - | - | 6.9×105 | |
| 黄色ブドウ球菌 | 検体 | 4.8×105 | <10 | <10 | <10 |
| 対照 | 1.7×105 | - | - | 6.6×105 | |
| クロカワカビ | 検体 | 1.7×106 | <10 | <10 | <10 |
| 対照 | 8.0×106 | - | - | 1.1×106 | |
<10:検出せず
保存温度:室温
-:実施せず
対照:清製水(黄色ブドウ球菌は生理食塩水)
*菌液接種直後の対照の生菌数を測定し、開始時とした。
①Escherichia coli NBRC 3972(大腸菌)
②Staphylococcus aureus subsp. aureus NBRC 12732(黄色ブドウ球菌)
③Cladosporium cladosporioides NBRC 6348(クロカワカビ)
SCDLP寒天培地[日本製薬株式会社],混釈平板培養法,35℃±1℃,2日間
GPLP寒天培地[日本製薬株式会社],混釈平板培養法,25℃±1℃,7日間
試験菌株を普通寒天培地[栄研化学株式会社]で35℃±1℃,18~24時間培養した後,生理食塩水に浮遊させ、菌数が107~108/mlとなるように調製し,試験菌液とした。
試験菌株をPotato Dextrose Agar(Difco)で25℃±1℃,7~10日間培養した後,胞子(分生子)を0.005%スルホこはく酸ジオクチルナトリウム溶液に浮遊させ,菌数が107~108/mlとなるように調製し、試験菌液とした。
検体10mlに試験菌液を0.1ml接種し、試験液とした。
室温で保存し、1、5及び15分後に試験液をSCDLP培養[日本製薬株式会社]で直ちに10倍に希釈し、試験液中の生菌数を菌数測定培地を用いて測定した。
財団法人 日本食品分析センター調べ